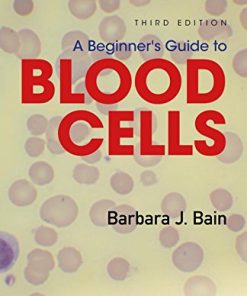
A Beginner’s Guide to Blood Cells, 3rd Edition (EPUB)

4 $
-
Newsletter

Sign up for Newsletter
Signup for our newsletter to get notified about sales and new products. Add any text here or remove it.
- MEDICAL EBOOKS
Buy Points Buy Points Discount 20% Buy Points
Styled Buttons for Mobile - Smaller Size -
0
Cart
Showing 19101–19120 of 34300 resultsSorted by latest